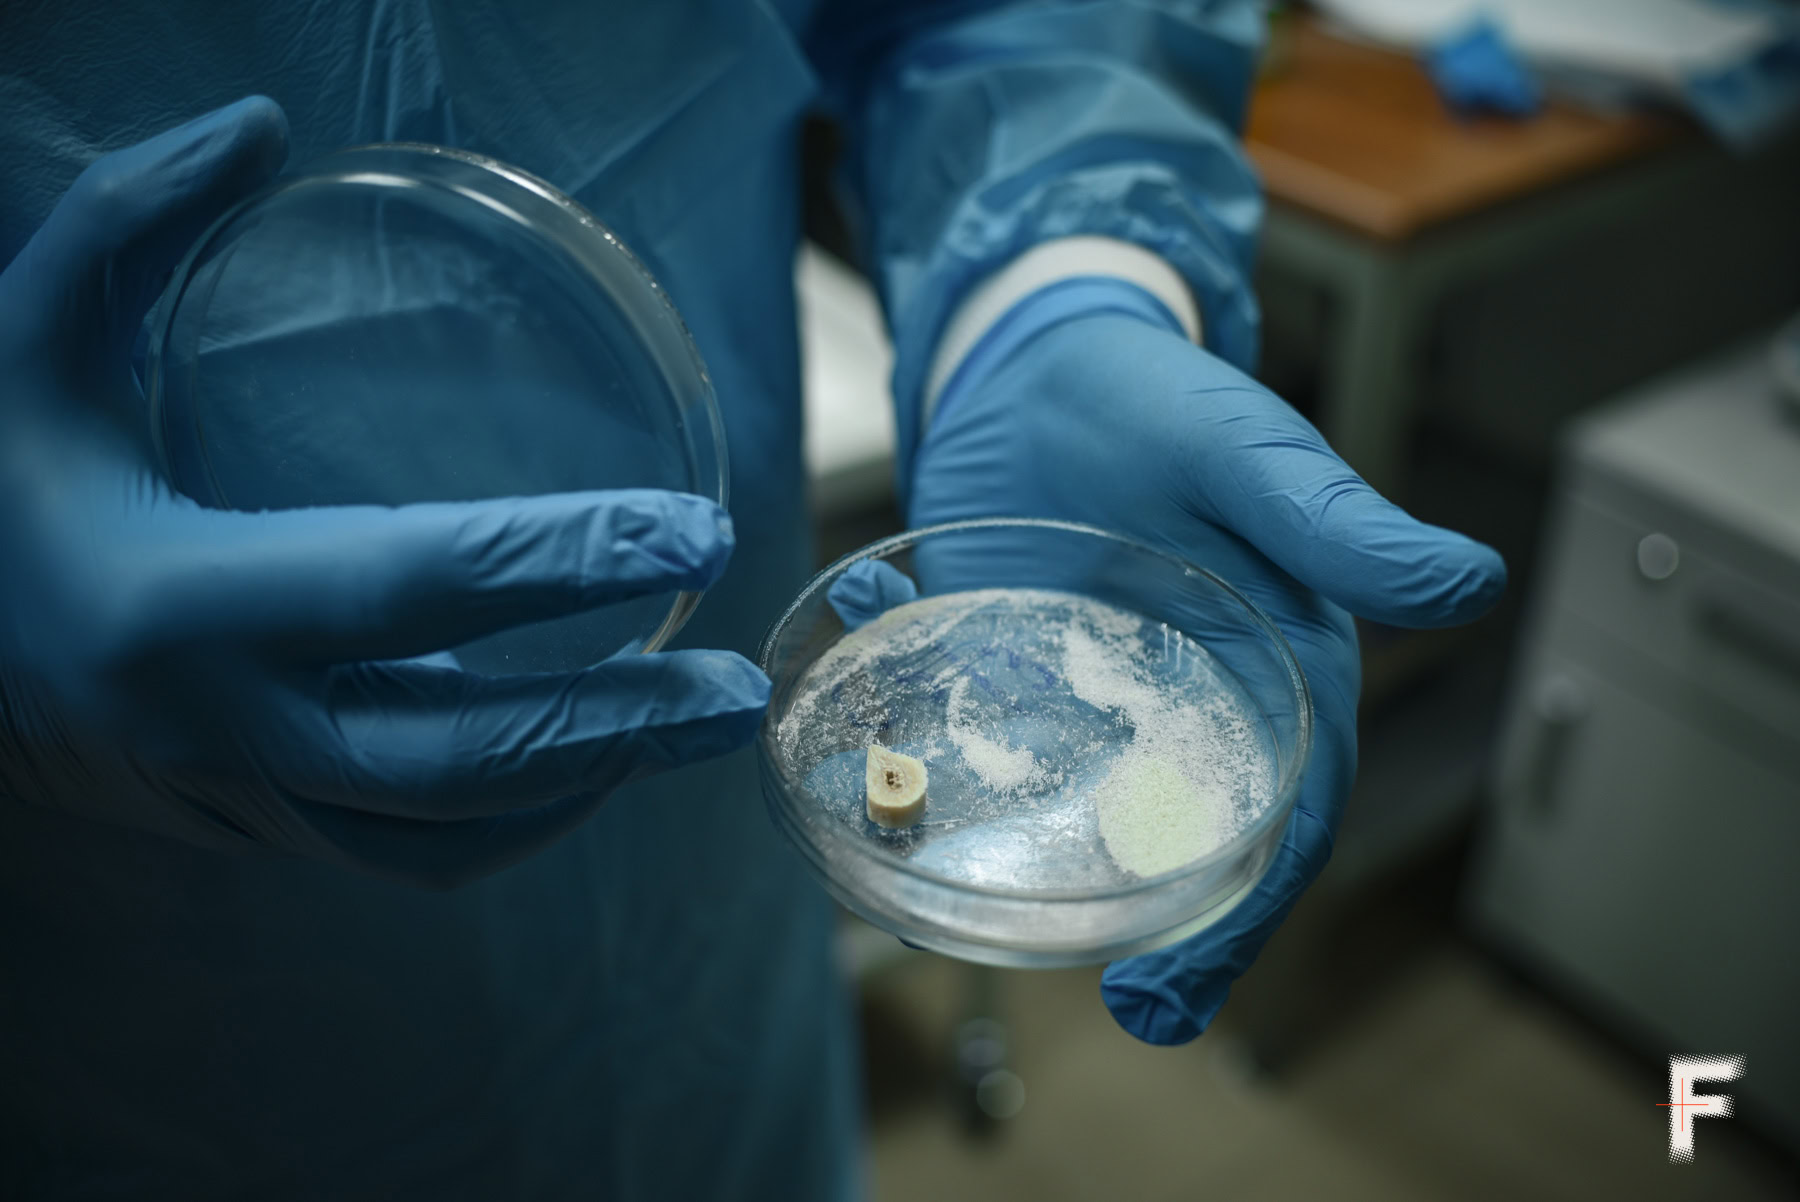

Імена, що чекають: як в Україні ідентифікують загиблих
Україна повертає своїх полеглих захисників додому. Але разом із тілами загиблих з’являється і складна робота – встановити, ким вони були. Ідентифікація загиблих стала одним із найважчих процесів війни: він потребує сучасного обладнання, витримки та психологічної стійкості від тих, хто щодня стикається з наслідками війни. Тіла переважно надходять у тяжкому стані, а іноді змішані між собою, тож кожен крок вимагає уваги й точності. Втім, саме ця праця дозволяє зберігати людську гідність. Frontliner розповідає як повертають загиблим їхні імена, а рідним – можливість попрощатися.
Процедура ідентифікації має кілька етапів: огляд і фіксація стану тіла, опис особистих речей, відбір біологічних матеріалів, лабораторний аналіз і подальший пошук збігів у базі ДНК. Для суспільства ці кроки залишаються майже непомітними, але для родин вони означають найголовніше – підтвердження долі їхніх близьких і можливість поховати їх з гідністю. Судмедексперти, криміналісти та санітари працюють у надскладних умовах, коли більшість тіл повертається з полону в стані пізніх трупних змін: муміфікованими, обгорілими чи у стані розкладу. Українська система, яка ще кілька років тому не була готова до таких обсягів роботи, сьогодні впроваджує власні рішення: від польових моргів та оптимізації черг ДНК-аналізів до розробки унікальної методики некродактилоскопії. Цей досвід важливий не лише для родин, які чекають повернення близьких, а й для всього світу, який має вчитися в України, аби створювати нові міжнародні стандарти, трансформуючи систему DVI (Disaster Victim Identification) відповідно до реалій воєнного часу.
З чого починається ідентифікація
Польовий морг, організований цією весною задля оптимізації логістики, розташований просто поруч із рефрижераторними вагонами, де зберігаються тіла. Тому, коли приїжджає нова репатріація, робота починається одразу. Люди у захисних комбінезонах розвантажують вагони, перевозять білі мішки до столів у наметі. Усередині мішка може бути будь-що.


«Ми не знаємо, що саме в пакеті й з чим доведеться працювати, – каже Тетяна Папіж, керівниця ДСУ «Одеське обласне бюро судово-медичної експертизи». – Може бути тіло, а можуть бути й фрагменти різних тіл, наприклад, чотири стопи».
Тіла розподіляють по секційних столах. Кожне проходить однакову процедуру: фотографування, опис зовнішніх прикмет, пошук документів або особистих речей. За можливістю, знімають відбитки пальців. Судмедексперт визначає причину смерті. Поруч слідчий фіксує дані у протоколах.
Кожне тіло отримує 17-значний ідентифікаційний номер. У ньому зашифровано все: дата прибуття, установа, що прийняла тіло, і порядковий номер. Це його нове ім’я до моменту, поки справжнє не буде відновлено.


«Перші сім репатріацій ми проводили просто в морзі, – пригадує лікар-судмедексперт Віктор Магрінчук. – Починаючи з восьмої, працюємо вже тут, у польовій лабораторії. У морзі ми могли опрацювати одне-два тіла за день, максимум три, бо першу половину дня займалися основною роботою, а вже потім переходили до репатріації. До того ж, доводилося чекати слідчо-оперативну групу, а столів у морзі бракувало».
Тепер масштаби зовсім інші: за день експерти опрацьовують близько сотні тіл.


Ми перші в Україні, хто організував таку роботу.
Гниття, обвуглення, муміфікація – тіла пролежали півтора-два роки, іноді довше. Візуально впізнати людину за таких умов майже неможливо. Все ж слідчі фіксують кожну деталь: від шнурків на взутті до татуювань, навіть частково знищених. Іноді шматок тканини, ключі, обручка або армійський жетон стають тим, що дозволяє звузити коло пошуку. Якщо такі речі є, їх фотографують, описують, пакують окремо й повертають у мішок разом із тілом. Особисті речі полеглого, якщо вони збереглися, важливі, але не визначальні. Вони не можуть замінити генетичної експертизи, проте іноді саме вони наближають момент, коли безіменний запис у протоколі перетворюється на конкретне ім’я.
Умови зберігання тіл та масштаб роботи
Часто вона знаходить час, щоб «вийти у поле» допомогти команді. Навантаження величезне: лише влітку Одеса прийняла 1600 тіл. Загалом від початку травня 2024 року прийнято одинадцять репатріацій, понад 2800 тіл.


Це тіла українських військових, повернених із Росії за обміном. Наймасштабніша репатріація за весь час повномасштабної війни складала 6000 тіл, з яких майже третину прийняла Одеса.
Тіла зберігаються у вагонах-рефрижераторах, температура всередині стабільна – мінус 10 градусів. Це тимчасове сховище, поки триває ідентифікація. Якщо протягом року не вдалось встановити особу, а всі лабораторні дослідження проведені, тіла ховають з усіма почестями на спеціально відведених ділянках. Там вони чекають свого збігу у базі ДНК родичів.


Це наша місія, ми зобов’язані її виконувати.
Біля кожного секційного столу працює команда: лікар судово-медичний експерт, лаборант, санітар, слідчий, оперативний співробітник, слідчий-криміналіст. Вісім столів, шість людей біля кожного. Також на території присутні фахівці ДСНС та НДЕКЦ (Науково-дослідний експертно-криміналістичний центр МВС України)і навіть вибухотехники. Разом – майже сотня фахівців.
«Влітку було особливо важко, – згадує керівниця бюро. – Люди втомлювались, ми просили кондиціонери, воду, біотуалети. Але ніхто не відмовився від роботи. Це наша місія, ми зобов’язані її виконувати».
Щоб отримати ДНК-профіль, потрібно від 14 діб до 21-ї. Час залежить від матеріалу – м’язової тканини, кістки чи хряща. Результати надходять у центральний реєстр, де їх чекають збіги з профілями родичів зниклих.
Система постійно вдосконалюється. Помилки трапляються, визнають фахівці, але кожна наступна репатріація проходить організованіше за попередню. Україна створює нову практику, якої досі не мала, – практику масової ідентифікації загиблих у війні.
Коли ДНК стає єдиним свідком
Після польового моргу – лабораторія. Тут триває другий етап ідентифікації, непомітний для більшості, але вирішальний. У спеціально обладнаних приміщеннях працюють експерти-генетики. Вони отримують пакети з кодами, без імен і історій, лише біоматеріал і службову інформацію: номер тіла, дата, регіон.
У кімнаті для роботи з речовими доказами все виглядає бездоганно чистим і впорядкованим. Тут проводять огляд речових доказів і підготовку їх для дослідження. На столах лежать фрагменти кісток, пробірки, контейнери. Руслан Кривда, керівник відділення молекулярно-генетичних експертиз, уважно дістає черговий пакет і показує підготовлений матеріал.
«Пакет отримується з локації з відповідними документами. В такому вигляді воно до нас приходить. У нас є відповідні методичні рекомендації Європейської комісії судових медиків, у яких прописано, що саме потрібно відбирати. В залежності від стану тіла ми беремо біологічні зразки. Тут відібрали дві ключиці, грудину (вже є на ній номер, ми її досліджували) і шийний відділ з першим хребцем», – пояснює він, показуючи на фрагменти.


На столі поруч – тазова кістка. «Ні хрящової, ні м’язової тканини не було – це скелетований труп, давність смерті більше ніж 12 місяців. Ми взяли перший хребець, механічно очистили й відібрали фрагмент дужки. Для цього є спеціальний бокс третього-четвертого класу захисту, який убезпечує дослідника від збудників, наприклад, туберкульозу».
Від кістки до цифрового профілю
Для аналізу зазвичай використовують щелепу, ключицю, ребро або надколінник – ці частини швидше дають результат. Зразки очищають, потім із них виділяють ДНК. Зуби або фрагменти кісток руйнують до порошку. Цей матеріал переносять у пробірку для подальшого виділення ДНК.
Усі профілі аналізують за 24-ма локусами (це певна ділянка на хромосомі, де розташований конкретний ген або інша унікальна частина ДНК. Це свого роду адреса всередині генетичного коду. Саме за цими «адресами» фахівці порівнюють ДНК різних людей, щоб встановити, чи є між ними спорідненість або чи належать зразки одній і тій самій особі), за міжнародним стандартом, що дозволяє точно встановити збіг. Дані вносять до Єдиного реєстру геномної інформації людини (ЄРГІЛ), створеного МВС. Саме там зберігаються тисячі ДНК-профілів родичів зниклих безвісти.


Важливо, щоб ДНК була стабілізована, у відповідній кількості та відповідній якості. Тому спочатку проводять етап встановлення якісних та кількісних характеристик, а потім стабілізують, щоб запобігти зайвим витратам дороговартісних матеріалів. Якщо ДНК зруйнована або матеріал непридатний, експерти запитують нові зразки, і тоді доводиться відбирати фрагменти повторно. Впливають температура, умови зберігання, час, що минув після загибелі. Часто роботу ускладнює навіть найменша деталь: фрагмент, змішаний з іншим тілом, або залишки землі, що заважають виділити чисту ДНК. Нажаль, більшість останків репатрійованих Росією тіл у дуже поганому стані.
У цій роботі обладнання має не менше значення, ніж руки, що ним керують. Завдяки допомозі донорів та партнерів експерти отримують сучасні аналізатори для молекулярно-генетичних досліджень, дороговартісні реактиви, витратні матеріали та інші інструменти, які полегшують роботу польових команд і прискорюють лабораторну експертизу.


«Це Genetic Analyzer 3500, повністю автоматична станція, все відкалібровано до міліметра. Вона автоматично видає точний профіль, – говорить Руслан Кривда і потім показує стару машину, яка стоїть осторонь. – Вона працювала ще з 2007 року, до того, як нам надали сучасні апарати».
Не менш важливим є навчання новим методам та роботі з новим обладнанням, яким теж опікуються донори та партнери.
Як Україна винаходить нові методи
Робота з ідентифікації не закінчується у лабораторіях. Паралельно зі щоденною роботою експертів розвивається ще один напрямок – навчання, обмін досвідом і пошук нових методів, які допомагають повертати імена швидше й точніше.
Цим напрямом опікується Romulus T. Weatherman Foundation, міжнародна гуманітарна організація, що допомагає українським фахівцям знаходити, ідентифікувати й репатріювати загиблих іноземних добровольців. Фундація координує пошук і транспортування тіл додому, допомагає створювати спільну систему стандартизованої ідентифікації, підтримує судово-медичні установи й навчає експертів новим методикам. Фонд також впроваджує інноваційні підходи: зокрема некродактилоскопію, розроблену українськими судово-медичними експертами у Вінниці. Цей метод дозволяє відновлювати відбитки пальців навіть у найважчих випадках: після обвуглення, муміфікації чи гнилісних змін.
За словами Ірини Хорошаєвої, директорки програми Warfare Victim Identification, яка координує пошук і репатріацію безвісти зниклих іноземних добровольців, робота фонду не обмежується технікою. Його команда супроводжує родини загиблих і зниклих безвісти: допомагає з відбором ДНК-зразків удома, юридичними процедурами, документами, судовими рішеннями. Для родин загиблих в іноземців це особливо важливо: лише офіційне встановлення факту смерті дозволяє змінити статус військовослужбовця, отримати свідоцтво про смерть і припинити податкові зобов’язання.
Місія фонду – повернути ім’я кожному загиблому й дати спокій родинам, які чекають, а також зміцнити систему гуманітарного реагування, що робить Україну прикладом для світу у питаннях гідного поводження з полеглими.
Коли цифри стають іменем
Зараз експерти працюють у спільній базі ЄРГІЛ (Єдиний реєстр геномної інформації людини, був створений для прискорення процесу ідентифікації репатрійованих тіл оборонців України та цивільних, які загинули внаслідок повномасштабної війни Росії проти України).


«Ми маємо доступ до бази ЄРГІЛ у МВС (Міністерство внутрішніх справ України є головним органом виконавчої влади, що координує пошук осіб, зниклих безвісти за особливих обставин – ред.), я попросила дозвіл офіційно. Тепер ми одразу бачимо, коли експертиза завершена, я телефоную слідчому: призначайте порівняльну, бо ми бачимо, що є співпадіння», – розповідає керівниця бюро Тетяна Папіж, як прискорюють процес – система оновлюється постійно, пошук збігів триває безперервно.
Порівняння проводять із профілями родичів, які здали зразки після повідомлення про зникнення близького.
«Стосовно порівняльних експертиз. Коли ми вносимо профіль в ЄРГІЛ, там знаходяться профілі родичів. Рідні зазвичай, коли отримують інформацію, що військовий пропав безвісти, здають зразки в лабораторії, і, коли відбувається співпадіння, то слідчий призначає порівняльну експертизу. Ми порівнюємо ДНК-профіль, який отримали з кісткового матеріалу, з ДНК-профілем родичів. Потрібно двоє родичів, щоб ми ідентифікували цю особу, – пояснює експерт генетик Ірина Ланцман, – найчастіше це мама й тато або двоє по лінії батька. Лише тоді ми можемо підтвердити збіг».


Коли збіг знайдено, робиться офіційний висновок, і тіло можна передавати родині. Якщо ж ні, і протягом року не вдається встановити особу, тіло ховають на спеціальній ділянці під тим самим індивідуальним номером. Так трапляється у випадку, коли немає з чим порівняти генетичний матеріал. Наприклад, якщо загиблий не мав рідних або вони перебувають на тимчасово окупованих територіях. Генетичний профіль при цьому зберігається, щоб колись, навіть через роки, табличка на могилі змінила номер на ім’я. Якщо ж особу загиблого встановлено, місія «На щиті» передає тіло родичам для подальшого поховання.
Система, що ще два роки тому не була готова до таких масштабів, сьогодні створює нові стандарти. Українські експерти не лише працюють на межі можливостей, а й розробляють методики, яких не мав світ. Це досвід, що може стати основою для майбутніх міжнародних протоколів.
Авторка: Тетяна Крекер